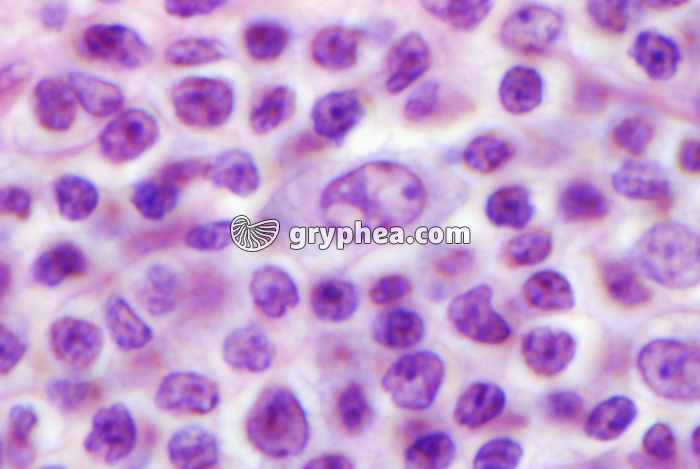
Ganglion lymphatique x800 - gryphea.org

Les photographies, infographies, vidéos, sons et textes publiés sur ce site ne sont pas totalement libres de droits. Vous pouvez les utiliser librement à titre personnel, dans la création de vos cours, compte-rendus, diaporamas, en respectant le watermark qui y est inclus, à la condition expresse d'avoir souscrit à un abonnement. Le contrat d’utilisation ne vous autorise cependant pas à diffuser ces documents ailleurs que dans le cadre strict de votre enseignement, et en aucun cas sur les réseaux sociaux. Merci de votre compréhension.
Pour accéder à tous les contenus de gryphea.org, aux photos haute définition et aux vidéos intégrales, profitez de nos offres d'abonnement :
Ce sont des nodules de petite taille (environ 800 chez l’être humain), situés sur le trajet des vaisseaux lymphatiques, où les cellules immunitaires se multiplient et se différencient. Ils sont parfois regroupés dans des zones dites «stratégiques» , au niveau du cou, du thorax ou de l’abdomen, et de façon plus superficielle sous la peau, dans les régions axilaire, occipitale et inguinale.
Basiquement, un ganglion comporte :
- une enveloppe externe appelée capsule qui forme des travées subdivisant la moelle en follicules, et reliée à des vaisseaux lymphatiques afférents et des vaisseaux sanguins,
une zone corticale, lieu de prolifération et de différenciation des lymphocytes B
un paracortex hébergeant des lymphocytes T et des cellules dendritiques,
un hile, lieu de départ d’un vaisseau lymphatique efférent et de vaisseaux sanguins
Les ganglions peuvent parfois s’hypertrophier : on parle alors d’adénomes ou d’adénopathies, ou être atteints par un[...]
La suite du commentaire est réservée aux abonnés